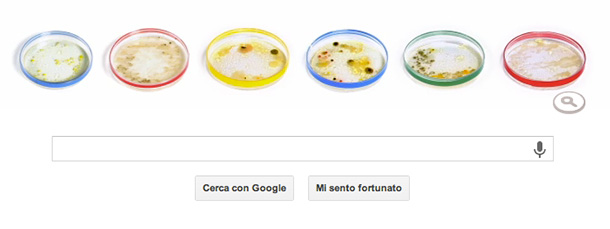
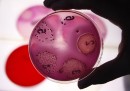
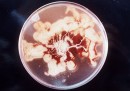
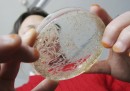

Julius Richard Petri e le sue piastre
Il microbiologo e medico tedesco è il protagonista del doodle di Google di oggi, per ricordare i 161 anni della sua nascita
Julius Richard Petri, ricercatore e batteriologo tedesco, è il protagonista del doodle di Google di oggi. Al posto del tradizionale logo, nella pagina principale del motore di ricerca c’è una animazione che rappresenta la piastra di Petri, il sistema utilizzato in tutto il mondo per effettuare le colture cellulari, in occasione del 161esimo anniversario della nascita del suo ideatore.
Nato il 31 maggio del 1852 a Barmen, in Germania, Julius Richard Petri studiò medicina presso l’Accademia per i medici militari dell’Imperatore Guglielmo, dove conseguì la laurea nel 1876. Proseguì gli studi alla facoltà di medicina della Charité a Berlino e prestò servizio più volte come medico militare fino ai primi anni Ottanta dell’Ottocento. Più o meno negli stessi anni, Petri divenne assistente di Robert Koch, grandissimo microbiologo che per i suoi studi sulla tubercolosi e sulla batteriologia sarebbe stato insignito nel 1905 del premio Nobel per la Medicina.
E proprio mentre lavorava nel laboratorio di Koch, Julius Richard Petri avrebbe avuto l’intuizione di realizzare un sistema più affidabile per effettuare le colture biologiche, inventandosi la piastra che ora porta il suo nome. Si tratta di un piatto di vetro (ma ormai capita di frequente sia di plastica) di forma cilindrica che viene sterilizzato e successivamente riempito con un terreno di coltura, cioè soluzioni liquide o solide che contengono sostanze nutritive utili per fare crescere e moltiplicare le cellule in laboratorio.
Nel corso degli anni, le piastre di Petri sono state utilizzate per altri scopi come l’osservazione della crescita dei germogli delle piante, per studiare il comportamento delle colonie di batteri o semplicemente per conservare e trasportare campioni all’interno dei laboratori. Le piastre di Petri di solito possono essere chiuse, ma non ermeticamente, per consentire all’aria di circolare e favorire la crescita cellulare, soprattutto nel caso delle colture batteriche. Il sistema è fatto però in modo da impedire ad altri microorganismi di penetrare nella piastra, evitando così contaminazioni dei campioni.
È opinione diffusa che, grazie al suo sistema, Julius Richard Petri abbia dato un contributo fondamentale allo sviluppo delle moderne tecniche di laboratorio per lo studio sulle colture cellulari. Petri morì a Zeitz nella Sassonia-Anhalt il 20 dicembre del 1921 a 69 anni, dopo avere dedicato buona parte della propria vita alla medicina e alla ricerca. Anche se milioni di ricercatori e tecnici di laboratorio in giro per il mondo si scambiano ogni giorno le sue piastre, Petri non viene ricordato spesso per il suo contributo dato alla scienza.
Il doodle di Google di oggi colma questa mancanza e gli rende omaggio con una interessante animazione. Le sei lettere del logo del motore di ricerca sono state sostituite con le immagini di altrettante piastre di Petri colorate. All’interno di ognuna è stata realizzata una coltura cellulare, avendo cura di posizionare i campioni in modo da dare alle colonie coltivate la forma delle lettere dalla “g” alla “e” di Google. Passando il puntatore su ogni piastra è possibile vedere l’origine dei campioni usati per l’esperimento, dai calzini usati alla tastiera di un computer passando per la maniglia di una porta.